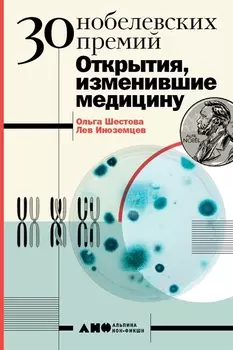
30 нобелевских премий: Открытия, изменившие медицину

-
None1037 ₽853 ₽-17%
None1037 ₽853 ₽-17%30 нобелевских премий: Открытия, изменившие медицину | Самая известная и почетная в мире премия — Нобелевская — ежегодно присуждается за выдающиеся научные исследования, революционные изобретения, кру...
-
 None1710 ₽1406 ₽-17%
None1710 ₽1406 ₽-17%Гроза двенадцатого года. Рассказы для детей об Отечественной войне 1812 года | Книга состоит из коротких рассказов, которые посвящены событиям Отечественной войны 1812 года. Они адресованы детям средн...
-
 None1179 ₽969 ₽-17%
None1179 ₽969 ₽-17%БОЛЬШАЯ КНИГА СКАЗОК ДЛЯ МАЛЫШЕЙ. ЛЮБИМЫЕ ПОТЕШКИ | Вы держите в руках удивительную книгу, внутри которой собрано множество потешек на все случаи жизни! С помощью весёлых коротких стишков вы сможете б...
-
 None759 ₽639 ₽-15%
None759 ₽639 ₽-15%Вот именно так и никак по другому | Новый том Дмитрия Воденникова — это всегда событие. И эта книга не исключение. Отдельные стихотворения и стихотворные циклы, уже вошедшие в сокровищницу русской лит...
-
 None1037 ₽853 ₽-17%
None1037 ₽853 ₽-17%Литература. 11 класс. Базовый уровень. Учебник. В двух частях. Часть 1 | Учебник входит в УМК для 10—11 классов А. К. Михальской, О. Н. Зайцевой «Литература». Особенностью курса является его тесная св...
-
 None825 ₽678 ₽-17%
None825 ₽678 ₽-17%Экспансия | Проникновение в чужие миры и знакомство с инопланетными технологиями, таинственные реликты и внеземные цивилизации, ожесточенные схватки магов и масштабные боевые баталии — Виктор никогда ...
-
 None376 ₽309 ₽-17%
None376 ₽309 ₽-17%Тонкая психология. Юмористические рассказы | Надежда Александровна Лохвицкая, «королева смеха», известная читателям под именем Тэффи, — яркая фигура в русской литературе первой половины XX века, автор...
-
 None1415 ₽1163 ₽-17%
None1415 ₽1163 ₽-17%Дети войны о войне | В книге представлены 40 оригинальных очерков – воспоминаний детей, на долю которых выпали тяжелейшие лишения в годы Великой Отечественной и Второй мировой войны. Впервые в отечест...
-
![Мне только спросить. Как болеть и лечиться правильно]() None1120 ₽560 ₽-50%
None1120 ₽560 ₽-50%Мне только спросить. Как болеть и лечиться правильно | Автор — самый популярный врач-терапевт, пульмонолог и победитель конкурса народного признания «Спасибо, доктор!», был награжден знаком «За мужест...
-
![Шерлок Холмс. Повести. Рассказы]() None2359 ₽1939 ₽-17%
None2359 ₽1939 ₽-17%Шерлок Холмс. Повести. Рассказы | Перу английского писателя, публициста и журналиста Артура Конан Дойла принадлежат исторические, приключенческие, фантастические романы и труды по спиритизму, но в мир...
-
![Князь Серебряный]() None263 ₽219 ₽-16%
None263 ₽219 ₽-16%Князь Серебряный | Вашему вниманию предлагается роман "Князь Серебряный" Толстого Алексея Константиновича для чтения в школе. None. Категория: Книги/Детские книги/Детская художественная литература/Пов...
-
![Неизвестный псевдоним Бога]() None742 ₽610 ₽-17%
None742 ₽610 ₽-17%Неизвестный псевдоним Бога | Наташа Петрова, уставшая женщина из провинциального города Н., не верит ни в себя, ни в свое возможное счастье. Но все меняет случайная встреча с одноклассником, и ее скуч...
-
![Капкан для золотого тельца (мягк) (Оборотни в законе). Казанцев К. (Эксмо)]() None155 ₽129 ₽-16%
None155 ₽129 ₽-16%Капкан для золотого тельца (мягк) (Оборотни в законе). Казанцев К. (Эксмо) | Это только кажется, что золото благородного желтого цвета. На самом деле — цвет кроваво-красный. Потому что за золотом всег...
-
![Кот в шляпе]() None589 ₽484 ₽-17%
None589 ₽484 ₽-17%Кот в шляпе | Вы слышали про Доктора Сьюза? Он пишет детские стихи и сказки, сам рисует к ним картинки и даже умеет делать мультики. Его книги переведены на множество языков и вот уже несколько десятк...
-
![Жизнь прекрасна! Посмотри! Часть 1]() None1415 ₽1163 ₽-17%
None1415 ₽1163 ₽-17%Жизнь прекрасна! Посмотри! Часть 1 | Стихи, в которых выражены разные события из нащей жизни. Которые подарят вам позитив и улыбку. Если книга придется вам по душе, я создам еще. None. Категория: Книг...
-
![Между прошлым и будущим]() None412 ₽339 ₽-17%
None412 ₽339 ₽-17%Между прошлым и будущим | Жизни двух сестер, Элеонор и Евы, изменил несчастный случай, полет, который длился всего несколько секунд, но перечеркнул все их мечты и взаимное доверие. Элеонор виновата пе...
-
![Преступление и наказание]() None565 ₽465 ₽-17%
None565 ₽465 ₽-17%Преступление и наказание | В книги этой серии входят произведения, включенные в школьную программу. «Преступление и наказание» Федора Михайловича Достоевского - одно из выдающихся произведений. Роман ...
-
![Строптивая невеста]() None107 ₽89 ₽-16%
None107 ₽89 ₽-16%Строптивая невеста | Последний отпрыск древнего благородного рода барон Гельмут Мансфельд приезжает в свой замок, чтобы вступить в наследство. По завещанию, оставленному его дедом, наследник обязатель...
-
![Литература]() None471 ₽387 ₽-17%
None471 ₽387 ₽-17%Литература | В книге приводятся все основные темы школьного курса литературы с 5 по 11 классы. Уникальная наглядная структура с активными полезными полями поможет оперативно найти и ознакомиться с нео...
-
![Авто Атлас Москвы и области (мягк) (Гео-Трейд)]() None365 ₽300 ₽-17%
None365 ₽300 ₽-17%Авто Атлас Москвы и области (мягк) (Гео-Трейд) | Обзорная карта Москвы; .Обзорная карта Московской области; .Фрагменты карт; .Условные обозначения; .Карты городов московской области; .Перечень городов...
-
![Невероятное везение]() None801 ₽659 ₽-17%
None801 ₽659 ₽-17%Невероятное везение | Наступили теплые майские деньки. До летних каникул совсем немного осталось. Но Даше и ее друзьям совсем не до каникул. Ведь им надо помочь тете Вите. У нее мошенники выудили нема...
-
![Одна на троих]() None978 ₽804 ₽-17%
None978 ₽804 ₽-17%Одна на троих | Попав на работу в компанию с очень сомнительной репутацией, я и представить не могла, что у меня будет три босса, и все трое проявят ко мне интерес, не только как к молодому, перспекти...
-
![Белые ночи]() None1061 ₽872 ₽-17%
None1061 ₽872 ₽-17%Белые ночи | Федор Михайлович Достоевский (1821 – 1881) еще в юности определил свою главную писательскую задачу: «Человек есть тайна. Ее надо разгадать, и ежели будешь ее разгадывать всю жизнь, то не ...
-
![Якоб, пора спать!]() None648 ₽533 ₽-17%
None648 ₽533 ₽-17%Якоб, пора спать! | Наступил вечер, и снова пора ложиться спать. Но Якоб совсем не устал! И всё-таки он принимает ванну, чистит зубы, потом вместе с Конни слушает сказку, которую им читает папа. И вот...
-
![365 стихов для детского сада]() None1297 ₽1066 ₽-17%
None1297 ₽1066 ₽-17%365 стихов для детского сада | Сборник "365 стихов для детского сада" адресован детям дошкольного возраста. В книге собрано триста шестьдесят пять стихотворений лучших детских поэтов: Агнии Барто, Бор...
-
![Мифопоэтика пространства и времени во французской литературе]() None1096 ₽901 ₽-17%
None1096 ₽901 ₽-17%Мифопоэтика пространства и времени во французской литературе | В монографии определяется мифопоэтика пространства и времени на материале французской литературы XIX в., а также поэтика отдельных авторс...
-
![Просто праздник!]() None1651 ₽1357 ₽-17%
None1651 ₽1357 ₽-17%Просто праздник! | Если в вашей жизни не хватает веселья и праздников, то эта книга стихов Артура Гиваргизова придётся как нельзя кстати! День здорового питания, День студента и Всемирный день пчёл — ...
-
![Лагерь]() None707 ₽581 ₽-17%
None707 ₽581 ₽-17%Лагерь | Книга Шварца и Пахомова была первой не только в биографиях писателя и художника, она также оказалась прорывом в книжном дизайне, образцом для последующих детгизовских опытов. Влияние В.Лебеде...
-
![Тюрьма для тысячи кукол]() None287 ₽239 ₽-16%
None287 ₽239 ₽-16%Тюрьма для тысячи кукол | С закрытием Комбината спокойная и размеренная жизнь Лады кончилась. Ее мать сумела устроиться горничной в дом местного крупного бизнесмена, и поначалу семья радовалась обилию...
-
![Германские мифы]() None860 ₽707 ₽-17%
None860 ₽707 ₽-17%Германские мифы | Немецкий фольклор, пышно расцветший на плодородной почве древнегерманской языческой и средневековой христианской культур, влюбил в себя многие поколения детей и взрослых, вдохновлял ...
-
![Детство (илл. Дехтерев) (ШБ) Горький]() None742 ₽610 ₽-17%
None742 ₽610 ₽-17%Детство (илл. Дехтерев) (ШБ) Горький | В книгу вошла первая повесть знаменитой автобиографической трилогии "Детство", "В людях", "Моиуниверситеты". В ней писатель рассказывает о трудных годах своего д...
-
![Выбор : роман]() None299 ₽249 ₽-16%
None299 ₽249 ₽-16%Выбор : роман | Любовь? Серьезные отношения? Ответственность? Семья? Закоренелый холостяк Трэвис Паркер считает, что все это не для него. У него есть отличная работа и верные друзья. Он увлекается охо...
-
![Кыш, Двапортфеля и целая неделя]() None860 ₽707 ₽-17%
None860 ₽707 ₽-17%Кыш, Двапортфеля и целая неделя | "Кыш, Двапортфеля и целая неделя" - увлекательная повесть Юза Алешковского. В ней много героев с забавными именами. Например, лохматого щенка зовут Кыш, а его друга А...
-
![Алиса в Зазеркалье]() None1061 ₽872 ₽-17%
None1061 ₽872 ₽-17%Алиса в Зазеркалье | «Алиса в Зазеркалье» – уникальное в мировой литературе произведение, по сей день не знающее себе равных. Написанная спустя шесть лет после «Алисы в Стране чудес», эта книга давно ...
-
![Омлет по-византийски: рассказы]() None2123 ₽1745 ₽-17%
None2123 ₽1745 ₽-17%Омлет по-византийски: рассказы | Гектор Хью Манро (1870–1916), более известный под псевдонимом Саки (что на фарси означает «виночерпий» или «кравчий» и, вероятно, заимствовано из рубаи Омара Хайяма), ...
-
![Случайная жертва]() None347 ₽289 ₽-16%
None347 ₽289 ₽-16%Случайная жертва | День рождения Натальи, праздник, который начинался как яркое и красивое торжество, закончился настоящей трагедией – убили младшую сестру хозяина дома Полину. Чистая и наивная девушк...
-
![Школа благородных мышей]() None1096 ₽901 ₽-17%
None1096 ₽901 ₽-17%Школа благородных мышей | Рассудительная мышка Мус, романтичная Смусси и решительная Фри - ученицы первого класса Школы благородных мышей. Случайно они обнаруживают тайный подземный ход, который ведёт...
-
![Большой весельчак]() None1356 ₽1115 ₽-17%
None1356 ₽1115 ₽-17%Большой весельчак | «Большой весельчак» — это сборник юмористических и философских произведений. Ироничные, пронзительные и глубокие, мастерски скроенные, они никого не оставят равнодушным. Здесь повс...
-
![Придурки: сборник]() None1120 ₽921 ₽-17%
None1120 ₽921 ₽-17%Придурки: сборник | В книгу вошли произведения знаменитого петербургского писателя и художника Дмитрия Горчева: избранные рассказы из разных циклов, сказки и пьесы. None. Категория: Книги/Художественн...
-
![Альбом ребёнка. Наш малыш - дар Аллаха]() None1037 ₽853 ₽-17%
None1037 ₽853 ₽-17%Альбом ребёнка. Наш малыш - дар Аллаха | Этот альбом станет для родителей источником радостных воспоминаний о первых годах жизни ребенка, а для малыша - первым руководством в жизни, и поможет осмыслит...
-
![Не Вконтакте. Стихи для детей]() None766 ₽630 ₽-17%
None766 ₽630 ₽-17%Не Вконтакте. Стихи для детей | Предлагаем вашему вниманию книгу "Не Вконтакте. Стихи для детей". None. Категория: Книги/Книги для детей/Детская художественная литература/Стихи и песни
-
![Она в моем сердце: роман]() None263 ₽219 ₽-16%
None263 ₽219 ₽-16%Она в моем сердце: роман | Новый год в зимнем лесу… Ели, припорошенные снегом, закатное солнце в легкой дымке… От здешней красоты дух захватывало. И вдруг… В первые секунды мы даже не поняли, что пере...
-
![Охотники на мамонтов. Поселок на озере]() None287 ₽239 ₽-16%
None287 ₽239 ₽-16%Охотники на мамонтов. Поселок на озере | Сергей Покровский — ученый-биолог, автор многочисленных научно-популярных очерков о природе. Однако известность к Покровскому пришла благодаря двум повестям, п...
-
![Околдованная]() None287 ₽239 ₽-16%
None287 ₽239 ₽-16%Околдованная | Как быть юной английской аристократке, которая вышла замуж за француза и вскоре осталась вдовой? Принять ухаживания короля Франции - и стать блистательной королевой Версаля? Или подарит...
-
![По прожилкам лиственной руки]() None459 ₽377 ₽-17%
None459 ₽377 ₽-17%По прожилкам лиственной руки | Песни самого романтичного нашего барда, добрые, светлые, задушевные, и интервью с ним собраны в этой книге. . None. Категория: Книги/Художественная литература/Российская...
-
![Промочили гуси лапки]() None107 ₽89 ₽-16%
None107 ₽89 ₽-16%Промочили гуси лапки | В удивительную серию "Книжки-малышки" вошли лучшие стихи, любимые сказки и интересные истории для детей. None. Категория: Книги/Детские книги/Детская художественная литература/С...
-
![Тихие песни уединения. Стихи разных лет]() None412 ₽339 ₽-17%
None412 ₽339 ₽-17%Тихие песни уединения. Стихи разных лет | «Тихие песни уединения» — новый сборник стихов иеромонаха Симона (Бескровного), подвизающегося ныне в одном из скитов Святой горы Афон. Несмотря на внешнюю бе...
-
![Атлас звездного неба с наклейками (45 наклеек) (м) (2 вида)]() None412 ₽339 ₽-17%
None412 ₽339 ₽-17%Атлас звездного неба с наклейками (45 наклеек) (м) (2 вида) | Дорогой друг! . .Приглашаем тебя в увлекательное путешествие по ночному небу! . .Маленькие мерцающие точки, которыми усыпано ночное небо, ...
-
![Мелодия для саксофона]() None311 ₽259 ₽-16%
None311 ₽259 ₽-16%Мелодия для саксофона | В квартире дочери убита тёща известного в городе саксофониста. Некто ударил женщину молотом. Полиция утверждает, что замок на входной двери не взломан. Получается, женщина сама...
-
![Снова поверить в любовь]() None179 ₽149 ₽-16%
None179 ₽149 ₽-16%Снова поверить в любовь | Мерида и Итан провели вместе одну страстную ночь. А спустя некоторое время она обнаруживает, что беременна. Узнав об этом, Итан предлагает ей подписать брачный контракт, по к...
-
![Честер - суперзвезда]() None565 ₽441 ₽-21%
None565 ₽441 ₽-21%Честер - суперзвезда | Для чтения взрослыми детям. None. Категория: Книги/Детские книги/Детская художественная литература/Повести и рассказы для детей
-
![Призрак кошки]() None766 ₽630 ₽-17%
None766 ₽630 ₽-17%Призрак кошки | Хорошо уехать из душного, затянутого смогом летнего Лондона в деревню! Плохо, что о доме, где поселилась Мейзи и её подруга Элис, ходят дурные слухи. Дескать, дело там нечисто – все ар...
-
![Нежданный гость]() None287 ₽239 ₽-16%
None287 ₽239 ₽-16%Нежданный гость | Представьте себе такую картину: путешественник, чей автомобиль в плотном тумане застрял на обочине одной из прибрежных дорог Южного Уэльса, ищет временное пристанище и помощь. Но ког...
-
![Один на миллион]() None251 ₽209 ₽-16%
None251 ₽209 ₽-16%Один на миллион | Земляне XXII века шагнули в космос, освоили другие планеты, но не решили своих проблем. И в космическом пространстве начинается новый этап противостояния военных флотов, империй, теп...
-
![Сила в старании]() None347 ₽289 ₽-16%
None347 ₽289 ₽-16%Сила в старании | Представлял ли когда-нибудь ваш ребёнок, что домашняя работа делается сама собой? Или что в комнате волшебным образом наводится порядок? А как насчёт того, чтобы мгновенно очутиться ...
-
![Хрон 48 минут. Начало]() None1710 ₽1406 ₽-17%
None1710 ₽1406 ₽-17%Хрон 48 минут. Начало | Это рассказ о людях, которые работают на телевидении. « - Если ты когда-нибудь подашь на меня в суд, то я буду вынуждена написать про тебя книгу. - Если ты когда-нибудь напишеш...
-
![Отрочество]() None287 ₽239 ₽-16%
None287 ₽239 ₽-16%Отрочество | Лев Николаевич Толстой (1828-1910) родился в имении Ясная Поляна Тульской губернии. Он был четвёртым ребёнком в большой дворянской семье. Его мать умерла, когда ему ещё не исполнилось и д...
-
![Школьный словарь. Цикады цитат. Цитатный минимум школьника.]() None978 ₽804 ₽-17%
None978 ₽804 ₽-17%Школьный словарь. Цикады цитат. Цитатный минимум школьника. | Словарь включает 350 цитат из произведений школьной программы по литературе и предназначен для того, чтобы обратить внимание на потенциал ...
-
![Magnum opus: сборник рассказов и малых повестей]() None1120 ₽921 ₽-17%
None1120 ₽921 ₽-17%Magnum opus: сборник рассказов и малых повестей | Magnum opus: сборник рассказов и малых повестей. None. Категория: Книги/Художественная литература/Российская литература/Современная российская проза
-
![Рассказы. Юморески (1880-1882). Том 1]() 892 ₽692 ₽-22%
892 ₽692 ₽-22%Рассказы. Юморески (1880-1882). Том 1 | Самые остроумные рассказы Антона Павловича Чехова. Рассказы, в которых он зло и беспощадно смеется над мещанством чиновников и коммерсантов, над восторженностью...
-
![После]() None530 ₽436 ₽-17%
None530 ₽436 ₽-17%После | Анна Тодд — американская писательница, феноменальную известность которой принес Wattpad. История, которую Тодд писала для души и публиковала в Интернете, собрала более 1 500 000 поклонников. И...
-
![Империя ангелов]() None801 ₽659 ₽-17%
None801 ₽659 ₽-17%Империя ангелов | Что там, наверху? Все души попадают в рай? Можно ли спасти человечество? Пионеры «послесмертных географических открытий» Мишель Пинсон и Рауль Разорбак встречаются снова, чтобы продо...
-
![Золотой жук]() None348 ₽160 ₽-54%
None348 ₽160 ₽-54%Золотой жук | В сборник включены лучшие произведения Эдгара По - психологические, детективные и фантастические рассказы и эссе, в том числе известнейшие: "Золотой жук", "Убийство на ули...
-
![Азовское море и Дон. Путеводитель]() None143 ₽119 ₽-16%
None143 ₽119 ₽-16%Азовское море и Дон. Путеводитель | Вашему вниманию предлагается путеводитель "Лучшие места для отдыха. Азовское море и Дон". None. Категория: Книги/Нехудожественная литература/Путешествия и туризм/Ат...
Учебники по литературе - распродажа
В категории "учебники по литературе" найдено товаров: 48371

























































